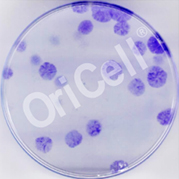
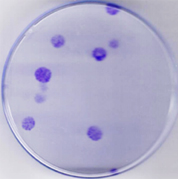
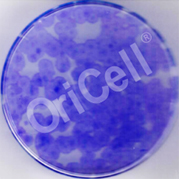

胎牛血清是许多细胞培养过程中必不可少的重要添加成分,其含有丰富的促生长激素、结合蛋白、酶、细胞因子等营养物质,为细胞的生长提供保证,但市面上胎牛血清种类繁多,质量良莠不齐,胎牛血清既是细胞培养的必备营养物,又是可能导致所养细胞死亡的“定时炸弹”,辛苦养起来的珍贵细胞可能因为用错血清而一切归零。
这不,为了解决科研人的烦恼,全方面满足实验的研究需求,拥有15年历史的科研干细胞供应商赛业OriCell® 经过严格的血清筛选,已有特级、标准级、去外泌体胎牛血清,现又上线了一款新品优级胎牛血清,血清源自新西兰,正规进口,手续齐全,经过多道分离、纯化、过滤工艺,质地纯净,内毒素及其他免疫原性蛋白含量极低,批间一致性高!经过了多种干细胞、原代细胞及细胞系的测试,其在细胞的形态、增殖速度、克隆形成能力等考察项目中均表现优秀,适合绝大部分干细胞、体细胞特别是间充质干细胞的取材、培养,及其他对血清质量有较高要求的实验研究。血清的选择直接关系到细胞实验的研发或生产进展,想要做好实验,好用的产品必不可少,赛业OriCell® 胎牛血清,你值得拥有!如需咨询订购,欢迎拨打400-680-8038或邮件至info@oricellbio.cn。
活动对象:科研终端客户
活动内容:
● 赛业OriCell®优级胎牛血清,新客户首单50mL399元就购了;
●
每人限购2瓶
![]() 正规进口:OriCell®
优级胎牛血清源自新西兰,正规途径批准进口,资质齐全。
正规进口:OriCell®
优级胎牛血清源自新西兰,正规途径批准进口,资质齐全。
![]() 质量可靠:OriCell®
经过了多种干细胞、原代细胞及细胞系的测试,其在细胞的形态、增殖速度、克隆形成能力等考察项目中均表现优秀。
质量可靠:OriCell®
经过了多种干细胞、原代细胞及细胞系的测试,其在细胞的形态、增殖速度、克隆形成能力等考察项目中均表现优秀。
![]() 高性价比:相同优质的产品中价格最实在,且稳定供货。
高性价比:相同优质的产品中价格最实在,且稳定供货。
![]() 适用范围广:适合绝大部分干细胞、体细胞特别是间充质干细胞的分离培养。
适用范围广:适合绝大部分干细胞、体细胞特别是间充质干细胞的分离培养。
| 产品名称 | 货号 | 规格 | 活动优惠 | 立即订购 |
|---|---|---|---|---|
| OriCell® 优级胎牛血清 | FBSSR-01021 | 50mL |
尝鲜价399元 |
|
| 500mL | —— |
赛业OriCell® 进口胎牛血清还包含特级、标准级和去外泌体血清,正规进口,筛选严格,批间一致性高,连连获得广大科研人员的称赞好评!
| 产品名称 | 货号 | 规格 | 立即订购 |
|---|---|---|---|
| OriCell® 特级胎牛血清 | FBSAD-01011 | 100mL | |
| 500mL | |||
| OriCell® 标准级胎牛血清 | FBSST-01033-500 | 500mL | |
| OriCell® 去外泌体血清 | FBSNE-01061 | 20mL | |
| 50mL |
由对比实验可看出,OriCell® 优级胎牛血清和国外某知名品牌在培养Human MSC、SD MSC、C57 MSC时血清质量相当。
Human MSC生长状态图




SD MSC生长状态图




C57 MSC生长状态图




克隆形成率

浙江大学 陈老师

山西农业大学山西省农业科学院 张老师

中山大学附属第一医院 徐老师

成都企业客户 刘经理

新乡医学院第二附属医院 郭老师

新乡医学院 牛老师
